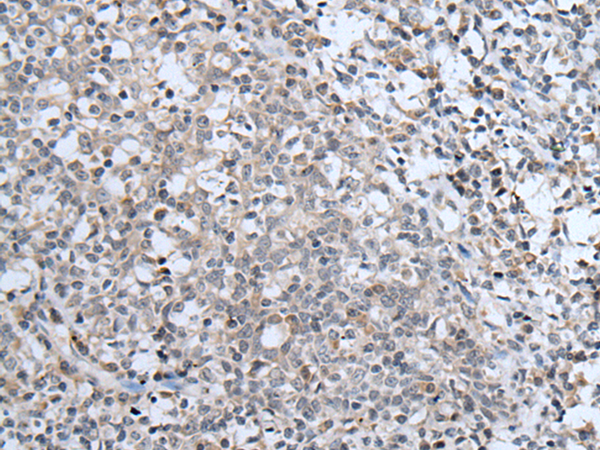

中文名稱: 兔抗ABCA6多克隆抗體
英文名稱: Anti-ABCA6 rabbit polyclonal antibody
別 名: EST155051
相關(guān)類別: 一抗
儲(chǔ) 存: 冷凍(-20℃)
抗 原: ABCA6
反應(yīng)種屬: Human
克隆類型: rabbit polyclonal
技術(shù)規(guī)格
|
Background: |
The membrane-associated protein encoded by this gene is a member of the superfamily of ATP-binding cassette (ABC) transporters. ABC proteins transport various molecules across extra- and intracellular membranes. ABC genes are divided into seven distinct subfamilies (ABC1, MDR/TAP, MRP, ALD, OABP, GCN20, and White). This encoded protein is a member of the ABC1 subfamily. Members of the ABC1 subfamily comprise the only major ABC subfamily found exclusively in multicellular eukaryotes. This gene is clustered among 4 other ABC1 family members on 17q24 and may play a role in macrophage lipid homeostasis. |
|
Applications: |
ELISA, IHC |
|
Name of antibody: |
ABCA6 |
|
Immunogen: |
Synthetic peptide of human ABCA6 |
|
Full name: |
ATP binding cassette subfamily A member 6 |
|
Synonyms: |
EST155051 |
|
SwissProt: |
Q8N139 |
|
ELISA Recommended dilution: |
5000-10000 |
|
IHC positive control: |
Human tonsil |
|
IHC Recommend dilution: |
30-150 |
購(gòu)物車
幫助
021-54845833/15800441009
